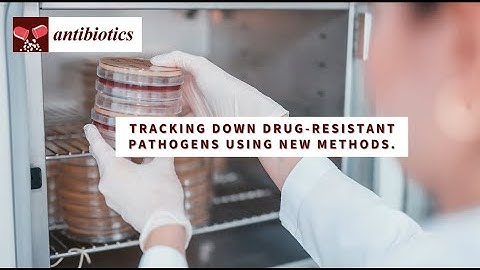
Tracking Down Drug-Resistant Pathogens Using New Methods.

⬇ DOWNLOAD NOW
Kalau muncul iklan pop-up, tutup lalu klik tombol kembali
Download lagu EtherTAP2 and Manual Trigger - Permanent Passive diagnostics & PCAP files on-demand secara gratis hanya untuk keperluan promosi. Dukung artis favorit kamu dengan membeli musik original di iTunes atau platform resmi lainnya.
 Ingesting Traffic: Uploading PCAP for Analysis
Ingesting Traffic: Uploading PCAP for Analysis
 Preparation & Inspection of the 20th IFRC 2023 Site with PERTAPINDO, ESDM, and The Assessors Team
Preparation & Inspection of the 20th IFRC 2023 Site with PERTAPINDO, ESDM, and The Assessors Team
Tracking Down Drug-Resistant Pathogens Using New Methods.
Tracking Down Drug-Resistant Pathogens Using New Methods.
 H9E1 Access to further Documentation and Support
H9E1 Access to further Documentation and Support
 What Is A Protocol Analyzer? - SecurityFirstCorp.com
What Is A Protocol Analyzer? - SecurityFirstCorp.com
 10 | OpenIPDM Inspectors toolbox
10 | OpenIPDM Inspectors toolbox
 Solution Duo I S1E5 I Why do I get Error Frames using the canAnalyser with my USB-to-CAN V2 Adapter?
Solution Duo I S1E5 I Why do I get Error Frames using the canAnalyser with my USB-to-CAN V2 Adapter?
 Solution Duo | S2E4 I How can I check the CAN signal levels of the USB-to-CAN V2?
Solution Duo | S2E4 I How can I check the CAN signal levels of the USB-to-CAN V2?